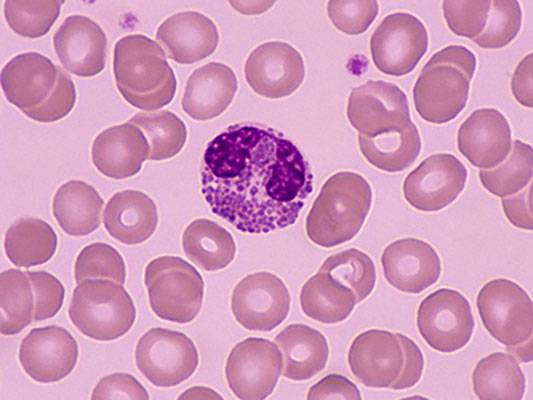
嗜酸性粒细胞(血液细胞)

嗜酸性粒细胞(血液细胞)
的有关信息介绍如下:
人体中正常成熟的白细胞可以分为五类:中性粒细胞、嗜酸性粒细胞、嗜碱性粒细胞、淋巴细胞和单核细胞。嗜酸性粒细胞是白细胞的组成部分,与其他粒细胞一样来源于骨髓的造血干细胞。嗜酸性粒细胞具有杀伤细菌、寄生虫的功能,也是免疫反应和过敏反应过程中极为重要的细胞。嗜酸性粒细胞可以释放颗粒中的内容物,引起组织损伤,促进炎症进展。血液中嗜酸性粒细胞的数量表现为昼夜周期性波动。清晨细胞数减少,午夜时细胞数增多。这种细胞数的周期性变化是与肾上腺皮质释放糖皮质激素量的昼夜波动有关的。当血液中皮质激素浓度增高时,嗜酸性粒细胞数减少;而当皮质激素浓度降低时,嗜酸性粒细胞数增加。
想要了解更多“嗜酸性粒细胞(血液细胞)”的信息,请点击:嗜酸性粒细胞(血液细胞)百科



